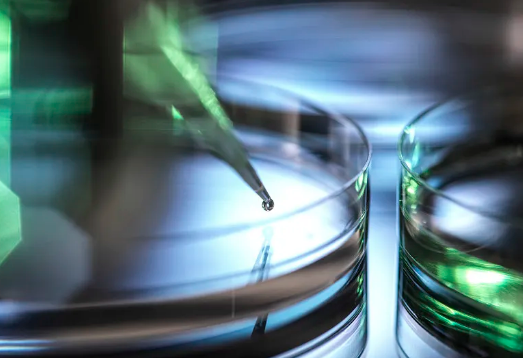
image.png

乳牙干細胞作用是什么,作用原理詳解
2024-09-20 14:51:11 來源: 小編 咨詢醫(yī)生
乳牙,即兒童的第一套牙齒,通常在6至12歲之間逐漸被恒牙替代。盡管乳牙會在生長過程中脫落,但近年來的研究顯示,乳牙不僅僅具有牙齒的生物功能,它們的干細胞也在醫(yī)學和生物學上具有重要的應用潛力。
1.乳牙干細胞的來源
乳牙干細胞(Dental Pulp Stem Cells,DPSCs)主要來源于乳牙的牙髓組織。牙髓細胞是一種具有多態(tài)性的細胞,能在體外條件下分化為多種細胞類型,包括成骨細胞、軟骨細胞和神經(jīng)細胞等。這種特性使得乳牙干細胞在再生醫(yī)學及組織工程中展現(xiàn)出獨特的應用價值。
2.乳牙干細胞的生物活性
乳牙干細胞具備自我復制和分化的能力。它們可以在體外培養(yǎng)的條件下進行擴增,同時保留原有的多能性。研究表明,DPSCs能夠分泌多種生物活性因子,促進細胞增殖和組織修復,這些生物因子包括生長因子、細胞因子等,能有效促進損傷組織的再生。
3.乳牙干細胞在再生醫(yī)學中的應用
乳牙干細胞有潛力應用于多種醫(yī)學領域:
牙齒再生:通過DPSCs的分化,可以幫助開發(fā)出牙齒再生的治療方法??蒲袌F隊正在探討如何將這些干細胞應用于齲齒和牙齒缺失的修復。
骨再生:DPSCs的成骨分化能力使其在骨再生中的應用前景廣闊。研究人員正在探索將乳牙干細胞用于骨缺損或骨折的修復。
神經(jīng)再生:DPSCs也表現(xiàn)出分化為神經(jīng)細胞的能力,這為神經(jīng)損傷的治療提供了新的思路,尤其在脊髓損傷和中風后的康復中。
4.乳牙干細胞的作用原理
乳牙干細胞的作用原理主要包括以下幾個方面:
細胞間信號傳導:DPSCs通過分泌細胞因子和生長因子,促進周圍細胞的增殖及分化。同時,它們還能夠調(diào)節(jié)免疫反應,減少炎癥反應,營造有利于組織再生的微環(huán)境。
微環(huán)境適應:DPSCs對微環(huán)境的響應能力使其在不同的病理狀態(tài)下都能發(fā)揮效用。它們能夠通過調(diào)節(jié)細胞外基質(zhì)的組成,促進損傷組織的愈合。
基因表達調(diào)控:研究發(fā)現(xiàn),乳牙干細胞在不同的生理和病理情況下會表現(xiàn)出不同的基因表達譜,這為干細胞在具體臨床應用中提供了個體化的治療方案。
5.潛在挑戰(zhàn)和未來研究方向
盡管乳牙干細胞的應用前景廣闊,但在臨床應用中仍面臨一些挑戰(zhàn),包括細胞存儲技術、培養(yǎng)條件的標準化以及倫理問題等。未來的研究將集中在優(yōu)化干細胞培養(yǎng)技術、探索更廣泛的臨床應用及解決倫理問題等方面。
在科研進展的推動下,乳牙干細胞有望成為再生醫(yī)學的重要組成部分,幫助患者實現(xiàn)組織再生和修復的理想療法。
文章來源:https://www.2008eshop.cn/ganxibao/37746.html
-
上一頁: 干細胞生物治療腫瘤效果怎么樣
- 2024-08-03干細胞治療慢阻肺,干細胞治療慢阻肺效果怎么樣
- 2024-09-25干細胞治療什么疾病比較好,附治療疾病種類和效果
- 2024-10-282030年干細胞基因療法將有哪些突破?前景如何?
- 2024-10-30干細胞療法研究歷程簡介:哪個階段最有前景?
- 2024-11-05安徽糖尿病干細胞治療效果評估?
- 2024-10-26干細胞治療牙周炎效果好嗎?具體療法是怎樣的?
- 2024-08-13間充質(zhì)干細胞存儲的好處
- 2024-08-16干細胞面部抗衰多少錢一次能持續(xù)多久
- 2024-07-18干細胞能治愈肝硬化嗎,干細胞對肝硬化的作用和功效
- 2024-09-27干細胞透析價格如何?費用影響因素有哪些?
- 2024-09-23乳牙干細胞作用,乳牙干細胞能治什么病
- 2024-09-16干細胞療法上市藥物,中國批準的干細胞藥物
- 2024-09-24福建干細胞采集費用多少錢
- 2024-08-15腸癌干細胞療法能治愈嗎
- 2024-08-09干細胞療法治療腰突有希望嗎
- 2024-09-09卵巢早衰干細胞治療費用大概多少
- 2024-09-21干細胞抗衰老是真的嗎,帶你了解三大作用機理
- 2024-10-04義烏干細胞有何作用?與常見功效對比差異何在?
